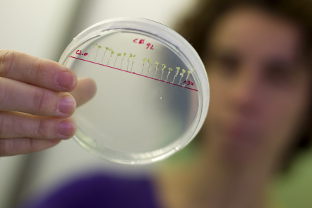
El gasto en I+D en Andalucía aumenta un 9,4% y crece un 23% la inversión privada

El gasto en I+D en Andalucía aumenta un 9,4% y crece un 23% la inversión privada en innovación
El gasto en I+D en Andalucía ascendió en 2010 a 1.726,7 millones de euros, un 9,4% más que el año anterior, un incremento muy por encima del registrado a nivel nacional, que prácticamente se ha mantenido respecto a 2009 (0,1%), según la 'Estadística sobre Actividades en I+D Año 2010’, elaborada por el Instituto Nacional de Estadística (INE).
De esta forma, Andalucía se sitúa como la segunda región que más ha aumentado su gasto en I+D el pasado año, por detrás de Baleares (10,5%), y la tercera comunidad en cuanto a recursos invertidos en términos absolutos, sólo superada por Madrid y Cataluña.
Andalucía invierte un 1,2% de su PIB en I+D, lo que la coloca en quinta posición en porcentaje del PIB empleado, sólo sobrepasada por Madrid, Navarra, País Vasco y Cataluña.
El gasto empresarial en I+D en Andalucía ha crecido en el último año un 23,5%, hasta los 619,4 millones de euros, rompiendo la tendencia de descenso registrada a nivel nacional (-0,8%) y la caída sufrida en este sector en la región en 2009 (-2,7%). La Enseñanza Superior también ha aumentado su inversión un 5,8%, hasta los 723,4 millones.
El sector de la Administración Pública andaluza ha ralentizado su ritmo de crecimiento, registrando un leve descenso (2%) respecto a 2009. Así, en 2010 el sector público aporta el 64% del total de la inversión, frente al 68% que suponía en 2009, mientras que el sector privado contribuye ya con el 36% restante, cuatro puntos más que el año anterior.
El freno de la inversión pública y el incremento de la privada está equilibrando la aportación de ambos sectores conforme al modelo de los países más avanzados, donde el sector empresarial gana peso alcanzando a la participación de las administraciones.
Las inversiones procedentes de Instituciones Privadas Sin Fines de Lucro (IPSFL) han sido las que registran una mayor caída, reduciéndose un 55,8% respecto a 2009.
En el reparto total de la inversión en I+D, el mayor esfuerzo por parte del sector público se realiza a través de los centros de Educación Superior andaluces, que suman el 40% del total regional, lo que sitúa a Andalucía como la segunda comunidad que más recursos destina a este segmento educativo a nivel nacional, sólo por detrás de Cataluña. Le sigue en aportación a la I+D la que realiza el sector empresarial, con 37,1% y la Administración Pública con 22,7% del total.
Andalucía es, en términos absolutos, la tercera comunidad en inversión pública en I+D y en número de personal y de investigadores al servicio de la I+D (25.774 personas), y la cuarta comunidad en inversión empresarial.
Resultado de una apuesta política
El consejero de Economía, Innovación y Ciencia, Antonio Ávila, ha destacado que este incremento de la inversión en I+D refleja que los "esfuerzos" del Gobierno andaluz por impulsar un nuevo modelo económico en la innovación y el conocimiento, que haga al tejido productivo más competitivo, está comenzando a dar sus frutos.
Ávila ha señalado el avance experimentado por el gasto innovador a pesar del contexto económico, un crecimiento que sitúa a Andalucía por primera vez en quinta posición en porcentaje del PIB empleado y la consolida como la tercera que más recursos destina a esta actividad en términos absolutos.
Este elevado crecimiento, ha afirmado, ha venido motivado en gran medida por el esfuerzo inversor del sector empresarial, lo que significa que "ha comenzado a calar en las empresas el mensaje de que la innovación les ayuda a mejorar su competitividad".
Junto a ello, el consejero ha indicado que el sector público continúa haciendo un esfuerzo importante por mejorar la innovación, especialmente a través de las universidades, siendo una de las comunidades que más recursos destina a este segmento educativo, de acuerdo con la apuesta que está realizando Andalucía por la educación superior como uno de los pilares para mejorar la competitividad de la economía.
Compartir en
 La consejería
La consejería
